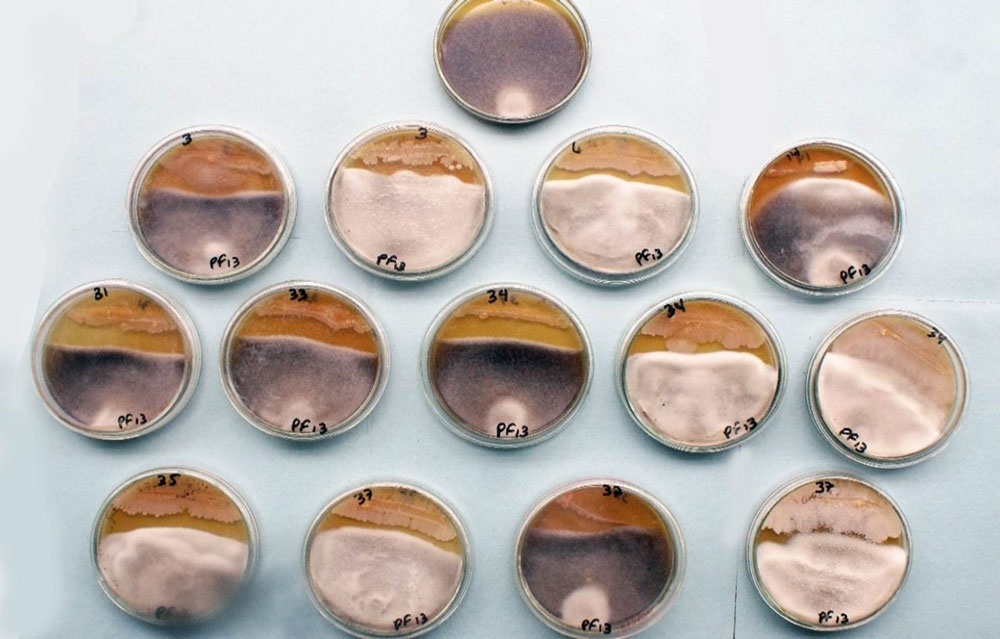
3. B. subtilis (Bs-4), 6. B. subtilis (Bs-21), 14. B. licheniformis (5-260), 31. Aislado 14 Bacillus spp. 33. Aislado E1 Bacillus spp. 34. Aislado E5 Bacillus spp. 34. Aislado E6 Bacillus sp. 37. B. subtilis (98,2) vs Bipolaris sp.

La revista Fitosanidad con e-ISSN: 1818-1686 | p-ISSN: 1562-3009 y e-RNPS: 2109 | p-RNPS: 0378, es fundada en 1999, es editada por el Instituto de Investigaciones de Sanidad Vegetal de Cuba. Está compuesta por un volumen anual bajo el sistema de publicación continuo (enero-diciembre) para aumentar la inmediatez de sus publicaciones. Desde su fundación, devino publicación de competencia en el área de la sanidad vegetal. Publica investigaciones originales e inéditas en españole inglés devenidas como artículos originales, comunicaciones cortas y artículos de revisión, en las especialidades de entomología, micología, virología, bacteriología, fitopatología, malezas, taxonomía, biología de plagas, métodos de diagnóstico, nuevos reportes de plagas, protección de cultivos; control químico y biológico, tecnologías de reproducción de especies benéficas, antagonistas y metabolitos con actividad biológica; en los campos de cuarentena vegetal; interacción patógeno-hospedante y resistencia genética; prácticas culturales; eficacia química, impacto ambiental y residuos de plaguicidas, ecología, epidemiología y pronóstico de plagas, medios y métodos de aplicación de plaguicidas, manejo de plagas y biología molecular.
Todos los documentos enviados son sometidos a un proceso de revisión por pares, a doble ciego, y emplea Open Journal Systems para gestionar sus contenidos en línea. Esta revista provee acceso gratis, libre e inmediato a su contenido, para fomentar mayor intercambio de conocimiento global. No establece períodos de embargo, ni cobra ningún arancel vinculado con el proceso de evaluación de pares, procesamiento o publicación de los documentos. Aquellos autores que tengan publicaciones en esta revista, aceptan los términos de la Licencia CC Reconocimiento-NoComercial 4.0 Internacional (CC BY-NC 4.0), bajo los cuales serán difundidos todos sus contenidos.
Número actual
Vol. 28 (2025): enero-diciembre
Publicado: 2025-01-01
Artículos Originales
Barreras vivas de maíz como reservorio de artrópodos benéficos en el cultivo de frijol: Diagnóstico y capacitación
https://cu-id.com/2109/v28e02
¿Es efectivo Bacillus thuringiensis Berliner en el control de Lissachatina fulica (Bowdich)?
https://cu-id.com/2109/v28e03
Plantas hospedantes de Megalurothrips usitatus (Bagnall, 1913) (Thysanoptera: Thripidae) en Cuba
https://cu-id.com/2109/v28e04
Actualización sobre la presencia de plagas en Casas de Cultivo Protegido en Cuba
https://cu-id.com/2109/v28e08
Ozono industrial para control de antracnosis y maduración en mango Tommy Atkins de exportación
https://cu-id.com/2109/v28e09
Actividad antagónica in vitro de Bacillus spp. frente a Macrophomina phaseolina y Bipolaris sp.
https://cu-id.com/2109/v28e13
Artículos de revisión
Consorcios microbianos y productos de cepa única. Potencialidades agronómicas y experiencias de uso en Cuba
https://cu-id.com/2109/v28e10